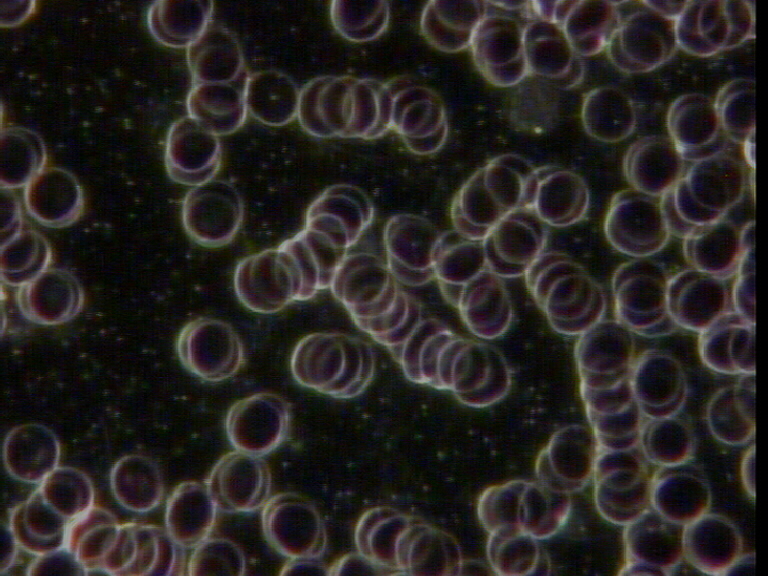
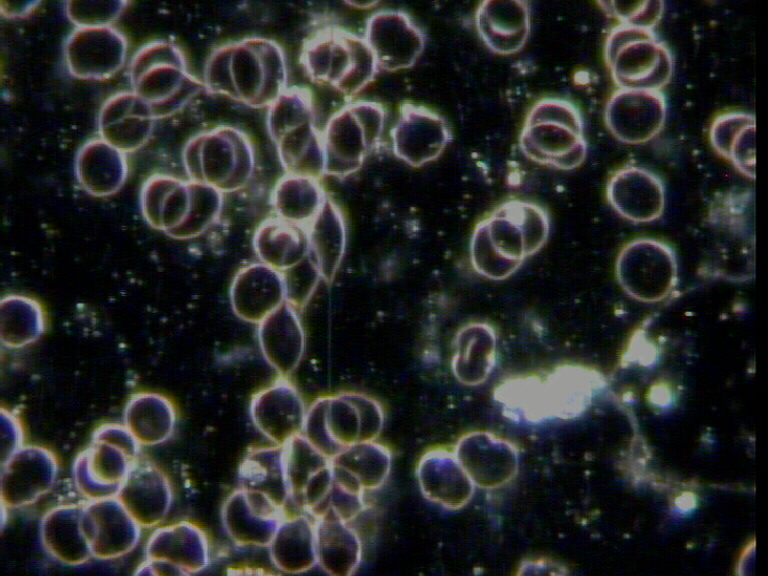

Torrblodsanalys
Blodprov tas genom ett enkelt stick i fingret, vilket ger ett kapillärblodprov. Några droppar blod placeras sedan på ett objektglas och får torka, vilket tar några minuter. Under denna tid genomgår blodet en koagulationsprocess som involverar 12 steg och är beroende av en rad olika näringsämnen såsom vitaminer, mineraler och proteiner samt diverse kemiska reaktioner.
Det färdiga blodprovet ger värdefull information om olika kroppsfunktioner och näringsbalansen. Det torkade blodet analyseras därefter i mikroskop direkt på kliniken, där man kan identifiera en mängd olika tecken och indikationer.
Vad kan man se i en torrblodsanalys?
Man kan bla. se
- Störningar i matsmältning och näringsupptag
- Problem med kroppen
- utrensningsfunktioner
- Fria radikaler (skadliga syreföreningar)

Levande blodanalys
Levande blodanalys genomförs genom att sticka klienten i fingret för att samla upp ett par droppar blod. Dessa bloddroppar placeras på ett objektivglas och undersöks sedan under ett mikroskop. Mikroskopet är kopplat till en extern skärm, vilket möjliggör för klienten att se sitt blod i realtid samtidigt som vi går igenom vad våran terapeut ser.
Analysen utförs med hjälp av mikroskop och specifikt mörkfältsteknologi, som avslöjar många olika hälsofaktorer. Under analysen undersöker vi bland annat cellernas storlek, aktivitet och form, samt olika ämnen som finns i blodplasman. Denna typ av blodanalys är ett verktyg som ger viktig information om ditt hälsotillstånd, snarare än att fungera som en metod för att diagnostisera sjukdomar.
Vad kan man se i en levande blodanalys?
Man kan bla. se
- En levande mikroskopisk blodanalys kan användas som underlag vid näring och kostrådgivning
- Skador av onda positivt laddade fria radikaler
- Riskfaktorer för proppar och kärl- och hjärtbesvär
- Näringsbrister, t.ex brist på vitamin B-12 och folsyra
- Urinsyrakristaller, kolestrol och blodsocker
- Bakterier
- Svampinfektion (Candida)
- Nedsatt leverfunktion
- Kvalitet på röda blodkroppar (Färg, form och storlek)
- Mag-tarmproblem (matsmältningsstörningar), enzymbrist
- pH-nivå och konsekvenser för kroppen
- Aktivitetsnivån på immunförsvaret (vita blodkroppar)
Boka en analys hos oss
Boka tjänst
Boka tjänst via formuläret nedan eller ring oss på 076 161 5758

Hos oss kan du använda Epassi för att nyttja ditt friskvårdsbidrag från din arbetsgivare. Alla våra tjänster täcks av Skatteverket satta regler för friskvårdsbidrag, även onlinetjänster.

Förkylning
Hjärta & Hjärna
Klimakteriet & Hormonbalans
Led & Muskelbesvär
Mage & Tarm
Prostathälsa
Sömn & Avslappning